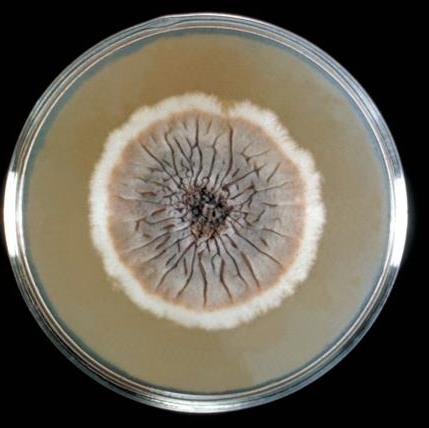
Sporothrix schenckii growing on Sabouraud agar (Image source: CDC) - Sporothrix schenckiigrowing on Sabouraud agar (Image source: CDC)

Sporothrixis a medically important dimorphic fungus. It is a causative agent of an occupational disease, sporotrichosis, also called Rose Gardner’s Disease. Other species of Sporothrix that cause human infections are Sporothrix brasiliensis, Sporothrix globosa, and Sporothrix luriei.
Sporothrix Overview
| Natural Habitat | Soil, plants |
|---|---|
| Infectious form | Conidia/hyphae |
| Mode of Transmission | Trauma, rarely inhalation |
| Common site of infection | Skin and lymphatics, lungs, and meninges |
| Clinical form | Yeast |
| Size | 2-6 mm |
Pathogenesis
Transmission
Sprothrix schenckii has a worldwide distribution. Its natural habitat is living or dead vegetation. Humans acquire sporotrichosis infection through trauma (thorns, splinters, bites, or scratches), usually to the hand, arm, or leg.
Who is commonly affected by Rose Gardner’s disease?
Sporotrichosis is a chronic infection of subcutaneous tissues. It is an occupational disease of farmers, nursery workers, gardeners, florists, and miners. It is commonly known as a rose gardener’s disease. Bites or scratches of stray cats can transmit the infection with S. brasiliensis. Pulmonary infection may occur after inhalation of spores but is very rare.
Clinical Manifestations
The primary lesion begins as a small, nonhealing ulcer, often of the index finger or the back of the hand. Nodular lesions of the skin or subcutaneous tissues develop at the point of contact, which may later involve the lymphatic channels and lymph nodes. The subcutaneous nodules ulcerate to form an infection that becomes chronic. In rare cases, dissemination can occur.
In people with low immune status, Sporothrix can cause pulmonary infection, lymphocutaneous infection, arthritis, sinusitis, osteomyelitis, external otomycosis, conjunctivitis, and even meningitis (rarely).
Lab Diagnosis of Sporotrichosis
Clinical specimen: Exudate aspirated from unopened subcutaneous nodules or from open draining lesions. Sporothrix can be recovered from respiratory secretions, skin, subcutaneous tissue, maxillary sinuses, synovial fluid, bone marrow, bone, CST, ear, and conjunctiva.
Direct microscopy
It is very difficult to observe the characteristics yeast form of Sporothrix schenckii in the clinical specimen. So the diagnostic significance of direct microscopy is significantly less.Sporothrix schenckii appears as small (2-5 ÎĽm in diameter), round to oval to cigar-shaped yeast cells. Periodic acid-schiff (PAS) method can be used to stain histological slides.

Culture
Colonies of Sprothrix schenckii grow rapidly (3-5 days) and maybe mistaken with yeast colonies. On further incubation, these colonies become membranous, wrinkled, dark brown, or black in color. The consistency of the colony may be leathery. Sprothrix schenckii hyphae are delicate, septate, and branching.
If the culture of Sprothrix schenckii is incubated at 37°C colony transforms into a soft, cream-colored white yeast-like colony (dimorphism). Conversion from mold form to yeast form takes place within 1-5 days. Flowerette arrangement of conidia (single-celled conidia borne in clusters from the tip of single conidiophore) is seen.

If the yeast-like colony is taken from a plate cultured at 37°C singly or multiply budding oval or elongate, cigar-shaped yeast cells are seen.
References and further readings
- Bailey & Scott’s Diagnostic Microbiology, Forbes, 11th edition